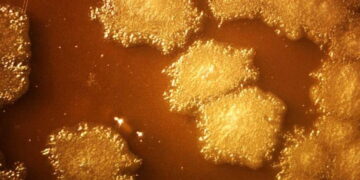
Kanser tedavisinde biyolojik devrim: Tümörü içeriden yok eden ‘akıllı’ bakteriler geliştirildi

HABER MERKEZİ – ABD, İstanbul Başkonsolosluğu’nda Suriye politikası üzerinde çalışan bazı üst düzey diplomatları görevden aldı.
Reuters’ta yer alan bir habere göre; Amerika Birleşik Devletleri (ABD), İstanbul’da faaliyet gösteren Suriye Bölgesel Platformu’nda (Syria Regional Platform -SRP) görevli bazı üst düzey diplomatları görevden aldı.
Kimliğini gizleyerek Reuters’a konuşan kaynaklar, SRP’deki bazı diplomatlara ekibin yeniden yapılanması kapsamında görev sürelerinin sona erdiğinin bildirildiğini söyledi. Kaynaklar görevden alınma kararının aniden verildiğini ve diplomatların “isteği dışında” olduğunu belirterek, ABD Başkanı Donald Trump’ın Suriye Özel Temsilcisi Tom Barrack’la diplomatların Suriye Demokratik Güçleri (QSD) ve Suriye Cumhurbaşkanı Ahmed el Şara’ya yönelik politikalarda anlaşamadığını iddia etti.
Bir başka kaynağın bu iddiaları yalanladığı ve görevden almaların ABD’nin Suriye politikasını etkilemeyeceğini aktardığı belirtildi. Kararın Barrack’la Beyaz Saray arasındaki görüş farklılıklarıyla ilgisi olmadığı aktarıldı.
ABD Dışişleri Bakanlığı’ndan bir yetkili “personele ilişkin kararlar ya da idari yeniden yapılanmalar” hakkında açıklama yapmadıklarını ifade ederek, “Suriye’ye ilişkin alanlarda çalışan ana ekip, çeşitli lokasyonlarda faaliyet göstermeye devam ediyor” dedi.
2012’de Şam’daki büyükelçiliğini kapatan ABD’nin Suriye’deki fiili misyonu olarak hizmet veren ve merkezi ABD’nin İstanbul Başkonsolosluğu’nda yer alan SRP’deki diplomatlar, ABD Başkanı Donald Trump’ın Suriye Özel Temsilcisi Tom Barrack’a bağlı çalışıyordu.
Kaynak: Mezopotamya Ajansı.
***Mutluluk, adalet, özgürlük, hukuk, insanlık ve sevgi paylaştıkça artar***